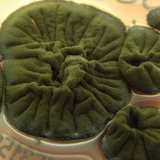

Odlična igra i izuzetno važna pobeda nad jakim protivnikom! 🔥🔥🔥🔥
Ženska rukometna reprezentacija Srbije pobedila je danas u Dortmundu selekciju Španije rezultatom 31:29 (17:19) u meču prvog kola Druge grupe glavne faze Svetskog prvenstva.
Najefikasnija u reprezentaciji Srbije bila je Jovana Jovović sa sedam golova. Aleksandra Vukajlović, Jovana Skrobić, Katarina Krpež-Šlezak su postigle su po pet golova, a Dragana Cvijić je dala četiri.
U redovima Španije istakla se Danila So Delgrado Pinto sa 11 golova, dok je Paula Arkos Poveda postigla četiri.


pročitajte još
PZD 📍 Zola OPLEO po Teodori i Bebici👀

pročitajte još
PACOVI mu nagurali 9KG LEŠNIKA ISPOD HAUBE 🌰🐀🤨
Autor: tanjug.rs